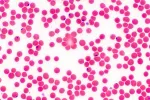
Frotis de sangre Diagnóstico de la enfermedad de Chagas

Tratamiento de la enfermedad de Chagas

Actualizado: 28 de junio de 2022
Principalmente hay dos tratamientos para la enfermedad de Chagas que, tradicionalmente, se han utilizado para curar la infección por tripanosoma. Ambos presentan limitaciones en el uso, especialmente debido a la aparición de reacciones adversas. Estos tratamientos son: nifurtimox y benzinidazol. Estos tratamientos están indicados de urgencia para cualquier persona en fase aguda y en casos de inmunosupresión, es decir en aquellos en los que se ha reactivado la infección. En estos casos, el tratamiento es efectivo casi al 100% y la enfermedad puede llegar a curarse por completo.
El benzinidazol se considera la primera línea de tratamiento para el Chagas, tanto por su mayor experiencia de uso y eficacia como por su perfil más seguro en cuanto a efectos secundarios. De estos efectos cabe destacar la aparición de exantema (enrojecimiento cutáneo) que responde bien a antihistamínicos, aunque en algunos casos puede causar dermatitis más complejas.
Por su parte, el nifurtimox –que es gratuito gracias a un acuerdo entre la OMS y Bayer– ocasiona con mucha frecuencia síntomas gastrointestinales como vómitos y pérdida de peso, aunque también origina trastornos neurológicos como temblores, desorientación y neuritis periférica. De hecjo, está contraindicado en pacientes con antecedentes de trastornos psiquiátricos o neurológicos.

Si el diagnóstico de Chagas se confirma, su médico especialista le pautará el medicamento más apropiado para usted. Consulte con su médico o farmacéutico todas las dudas que pueda tener acerca del medicamento que le prescriban.
Tratamiento del Chagas en enfermos crónicos y niños
Por otro lado, estos tratamientos son efectivos en la fase aguda de la enfermedad, pero en la fase crónica (especialmente tardía) no lo son tanto. Por ejemplo, la eficacia de este tratamiento es controvertida en la afectación de la infección crónica, en la afectación cardíaca (miocardiopatía), afectación gastrointestinal, y en la reactivación de la enfermedad en pacientes con las defensas disminuidas. Aún así, se establece que pueden disminuir la progresión de la enfermedad de Chagas. A pesar de esto, la mayoría de expertos no recomiendan tratar casos de Chagas en mayores de 55 años o con afectación cardiaca avanzada.
En cuanto al tratamiento especifico de la afectación de órganos concretos como corazón o aparato digestivo en estos pacientes, es necesario en ocasiones la implantación de marcapasos en la cardiopatía por Chagas, y la cirugía para extirpar parcial o totalmente el colon cuando se produce megacolon en situaciones muy avanzadas
Conviene también aclarar que no existen formulaciones de estos tratamientos para población pediátrica, lo que obliga a reformular los tratamientos de adultos.
Existen algunos ensayos recientes que están probando la eficacia de ravuconazol y posaconazol, todavía sin resultados definitivos ni incluidos en regímenes terapéuticos totalmente contrastados.
Creado: 24 de febrero de 2012